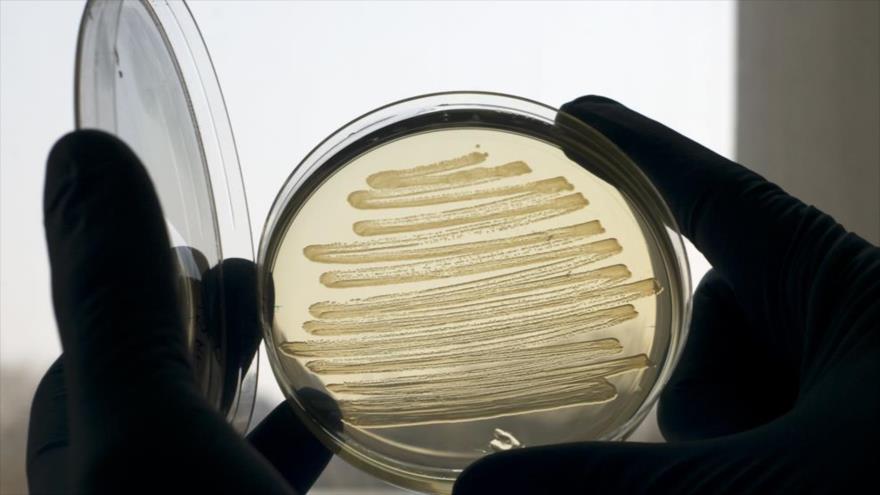
Las bacterias resistentes a los antibióticos fueron responsables de la muerte de 33 000 personas en la Unión Europea (UE) en 2015.

Según los cálculos de la investigación llevada a cabo por el Centro Europeo para la Prevención y el Control de Enfermedades (ECDC, en sus siglas en inglés), publicados el lunes en la revista The Lancet Infectious Diseases, para 2015 hubo 671 689 infecciones causadas por bacterias multirresistentes como “consecuencia de las cuales” murieron 33 110 pacientes.
Los investigadores elaboraron un modelo de cálculo para cinco tipos de infecciones a partir de datos de la Red Europea de Vigilancia de la Resistencia a los Antibióticos (EARS-Net, por sus siglas en inglés).
Ese impacto sobre la salud de la población ya es parecido al que suman las tres principales enfermedades infecciosas: la gripe, el virus de inmunodeficiencia humana (VIH) y la tuberculosis.
La mayoría de las muertes afectan a los niños menores de 12 años y a los mayores de 65 años. El impacto en términos de mortalidad es más elevado en Italia y Grecia (el primero concentra más de un tercio de los decesos), conforme al estudio.
El sector médico alerta constantemente del peligro del consumo excesivo o inadecuado de los antibióticos, que vuelve a las bacterias resistentes a estos.
tmv/anz/fmd/rba